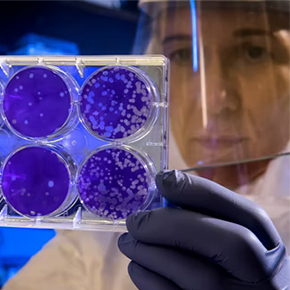

联系电话:029-81149983 公司邮箱:service@jadebioscience.com

地址:陕西省西安市长安区学府大街333号秦创长安创慧中芯产业园1号楼2层10201、10202、10203、10204室
电话:029-81149983
邮箱:service@jadebioscience.com
微信公众号
微信公众号
地址:陕西省西安市高新区锦业路69号创业研发园C区1号瞪羚谷A701
电话:029-81149983
邮箱:service@jadebioscience.com
Copyright © 2021 通域生物科技 版权所有. 陕ICP备2022008737号.
陕公网安备61019002002376号.
技术支持:迅响科技